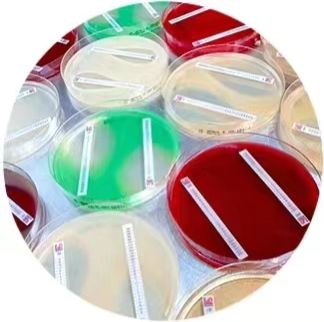
人神经胶质瘤细胞

相关产品推荐更多 >
万千商家帮你免费找货
0 人在求购买到急需产品
- 详细信息
- 文献和实验
- 技术资料
- 库存:
大量
- 保质期:
6 个月
- 供应商:
艾研
- 保存条件:
无血清细胞冻存液
- 规格:
T25
风险提示:丁香通仅作为第三方平台,为商家信息发布提供平台空间。用户咨询产品时请注意保护个人信息及财产安全,合理判断,谨慎选购商品,商家和用户对交易行为负责。对于医疗器械类产品,请先查证核实企业经营资质和医疗器械产品注册证情况。
文献和实验神经胶质瘤亦称胶质细胞瘤,简称胶质瘤。起源于神经间胶质、室管膜、脉络丛上皮、神经元等,起因至今未明,占颅内肿瘤40%左右。常见分类有:星形细胞瘤、星形母细胞瘤、多形性胶质母细胞瘤、少枝胶质细胞瘤、室管膜瘤、脉络丛乳头状瘤、松果体细胞瘤、神经元肿瘤及髓母细胞瘤。男性较为多见,可发生于不同年龄。临床表现主要有头痛、呕吐及视乳头水肿等颅内压增高症状及局限性神经损害症状。胶质瘤呈侵袭性生长,无包膜,分界不清,恶性程度各有不同。容易复发,晚期死于脑疝。到目前为止,治疗仍以手术为主,辅以
视神经胶质瘤为视神经或视交叉胶质细胞的原发性肿瘤,是儿童期最重要的眼眶肿瘤。多发于10岁以下,占眶内肿瘤的1—2%。该肿瘤实际上属于脑肿瘤,部分病例形成颅、眶沟通肿瘤。该瘤虽属良性到低度恶性肿瘤,并且发展缓慢,但因累及视神经或视交叉,临床上表现为无痛性进展性的视力丧失和眼球突出。视神经管及其后方视神经的肿瘤可能在视力丧失很久后尚无眼球突出。另外,视神经胶质瘤与神经纤维瘤有密切关系,40—50%伴有神经纤维瘤。视神经胶质瘤的治疗较为复杂,位于视神经处多考虑手术治疗,涉及视交叉
microRNA-195通过直接影响靶基因Cyclin D1和Cyclin E1的表达 抑制了人神经胶质瘤细胞的增殖
器,它可以调节多种靶基因的表达,引起肿瘤细胞中异常信号的传递,从而影响肿瘤的增殖。先前的研究发现,与人正常的星形胶质细胞和非肿瘤组织相比,miR-195在神经胶质瘤细胞系和人的早期胶质瘤组织中表达显著下调。上调miR-195的表达显著降低了神经胶质瘤细胞的增殖。流式细胞仪分析表明,miR-195的异常表达使S期细胞的百分数明显下降,G1/G0期细胞的百分数增多。过表达miR-195也显著降低了神经胶质瘤细胞的非依赖型锚定生长能力。而且,在神经胶质瘤细胞中,过表达miR-195也降低了磷酸化视网膜母细胞
技术资料暂无技术资料 索取技术资料